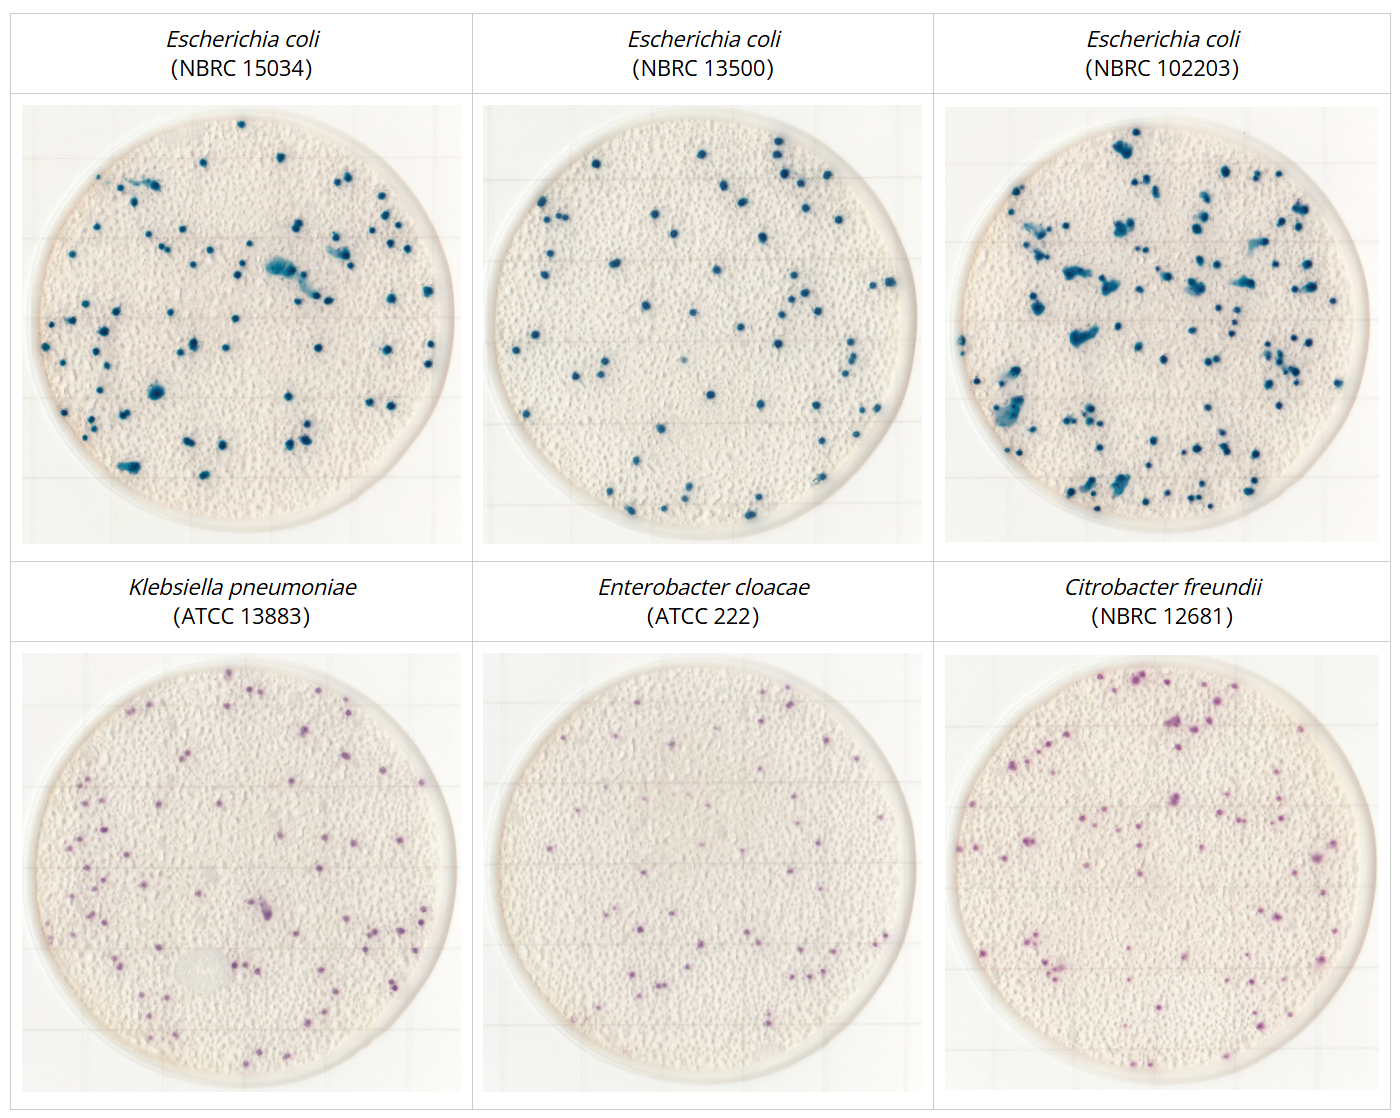
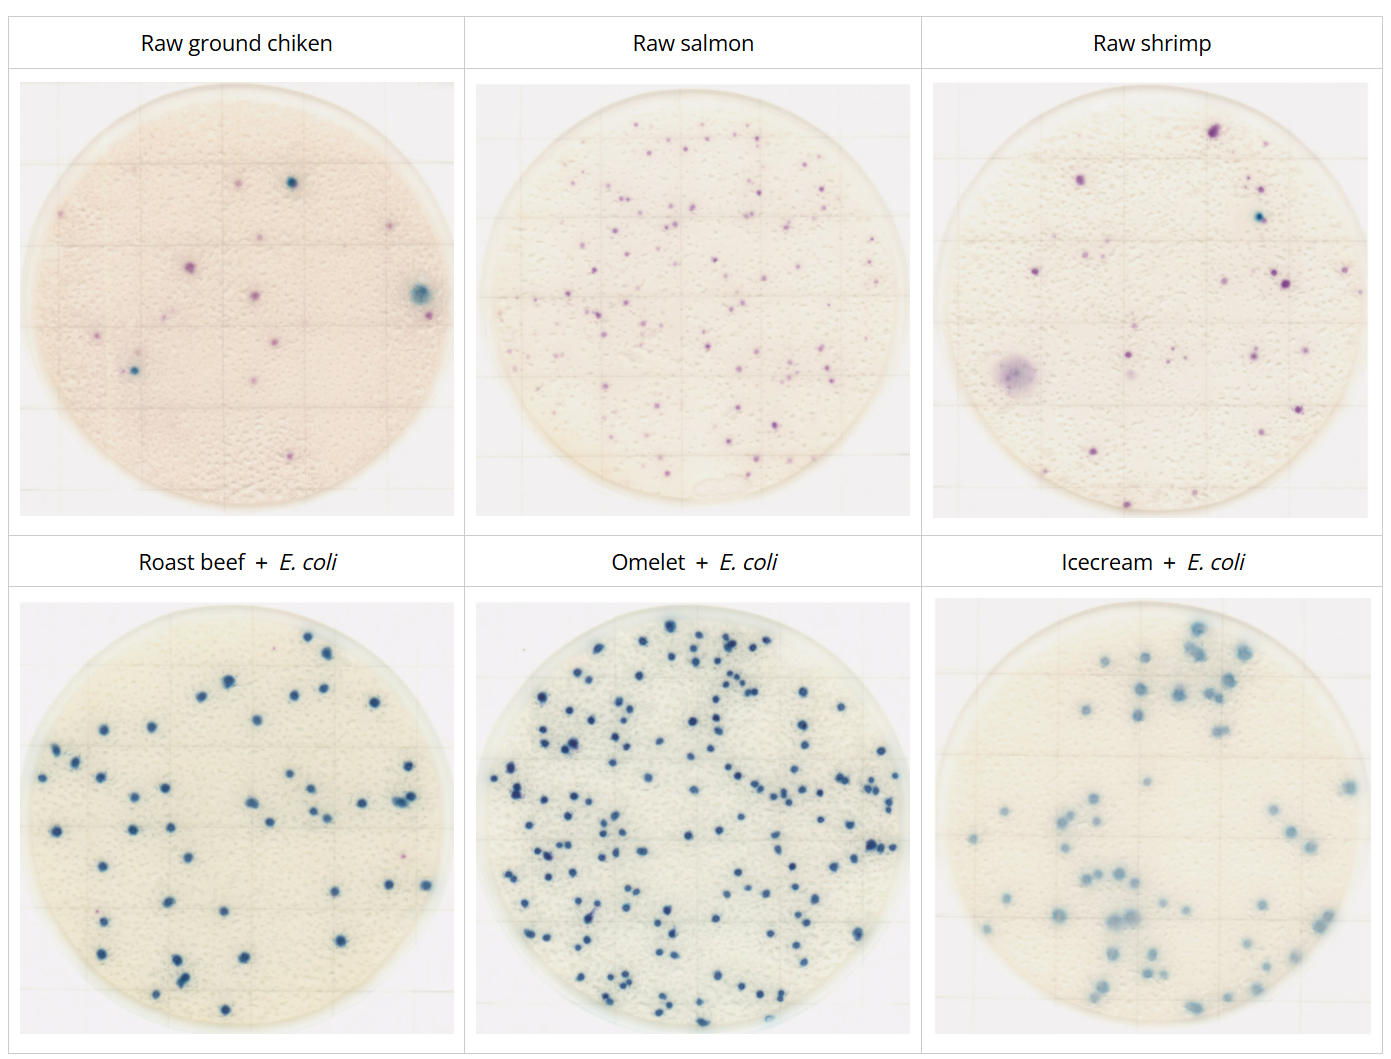

Description
Easy Plate EC is a custom media formulation that has obtained AOAC PTM certification. It is designed for the purpose of detecting, identifying, and enumerating both E. coli and non-E. coli coliforms. This microbial test kit consists of two chromogenic substrates that induce distinct colour changes in E. coli and non-E. coli coliforms, allowing for easy differentiation during analysis*. E. coli colonies exhibit a range of blue-purple to navy blue colours, while non-E. coli coliforms display pink to red-purple hues. This color variation aids in overcoming common interferences encountered during food and water testing, simplifying the process of testing and enumerating E. coli and coliforms. It is important to note that while most E. coli strains produce β-glucuronidase, E. coli O157 lacks this specific enzyme and therefore exhibits a red-purple colour similar to that of non-E. coli coliforms. This distinction should be taken into consideration when performing the analysis and drawing conclusions. Easy Plate EC has been certified by AOAC PTM and is available in packages containing 100 tests, divided into four separate bags, each containing 25 tests. When stored unopened at temperatures between 2-8℃, Easy Plate EC maintains its effectiveness for up to 18 months.
Features
1. Easy to distinguish bright-coloured colonies in just 24 hours
- Identifying is simpler in comparison to agar count media due to the colour change, making it unnecessary to confirm the presence or absence of air bubbles or the size of colonies.
- Incubation time is halved from 48 hours to 24 hours
- The use of Easy Plate only requires a single sheet, whereas the surface plating method typically needs three or more plates.
2.High correlation with the plate count agar
High correlation with the plate count agar in various foods. According to the research by DNP.
Coloring
Colonies of E. coli O157:H7
E. coli O157:H7 ATCC 43895
(Serotype O157H:7, verotoxin I- and II-producing strains)
Coloring of the plate surface caused by enzymes contained in foods
In some unheated foods and dairy products, residual enzymes in the food may cause a red-violet colouring to develop over the entire incubation area. If the visibility of the colonies is affected, improvement can be obtained using dilutions.
Example
Strains
Foods
Product Specifications
| Packaging | 100 tests (25 tests x 4 bags) |
| Object Microorganism | E. coli & Coliform |
| Incubation Times | 24 ± 1 hours |
| Incubation Temperature | 35 ± 1℃ |
| Storage Condition (Unopened) | 2 – 8℃ |
| Storage Condition (After opened) | After opening the package, fold the open end of the package at least 2 times and tape it. Store in a refrigerator (2 to 8°C) and use within 3 months. |
| Shelf life | 18 months after manufacturing date |
| Certification/Regulation | Certified by AOAC RI PTM, MicroVal, & NordVal |
For automated Easy Plate Colony Counting click here to view our Scanner!

Exportable Data and Reports for Regulatory Compliance


See how A3 technology finds what ATP technology can’t


